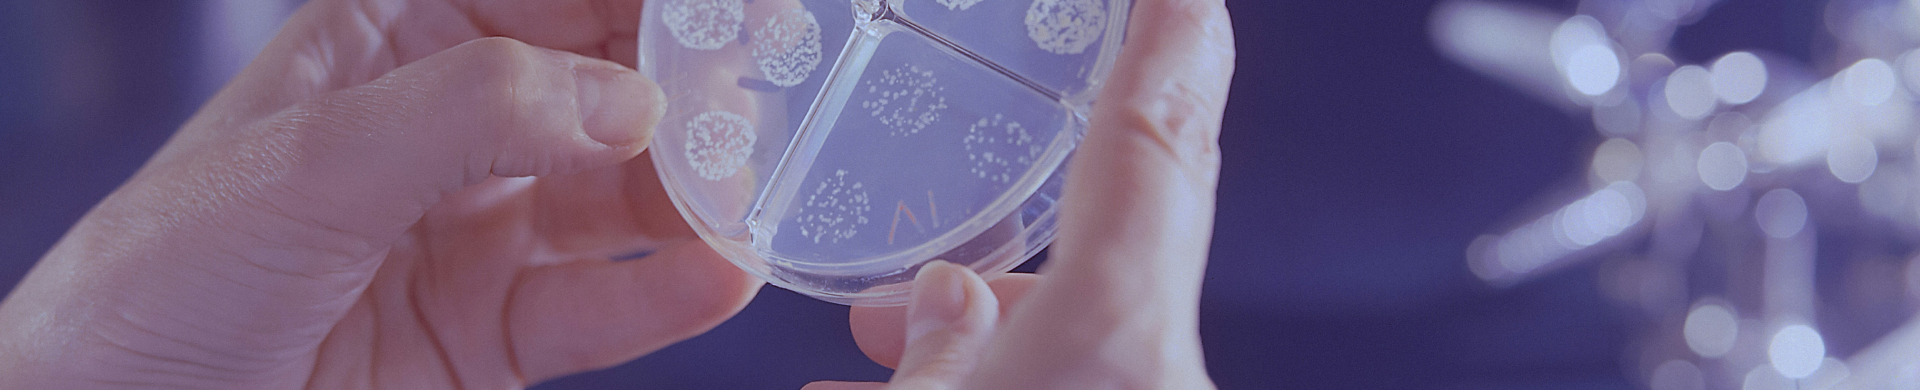

Our core values drive our operations in every respect:
Innovative academic programs
HIT is always on the lookout for new fields and new needs, aiming to provide cutting-edge responses to our fast-changing reality and its numerous challenges. Accordingly, we have now chosen to focus on the medical world, now undergoing huge and rapid transformations, by converging technology, medicine and design. To this end we intend to establish a new Faculty of Medical Technologies, which will include our unparalleled and already operational program in Digital Medical Technologies, alongside soon-to-be-established programs in Medical Imaging and Clinical Technologies.
Academia for Industry
HIT implements a core strategy of ‘Academia for Industry’: faculty and students work closely with Israeli and world-leading corporations, while programs and projects respond to real-world needs. About two thirds of our students are employed at high-tech or other companies as they study, and all of our students acquire hands-on experience through projects and collaborations with industrial corporations. Ultimately, once they graduate, HIT alumni are in high demand in Israel’s advanced technological marketplace.
Applied research
Researchers and students in all HIT Faculties apply their knowledge and capabilities to innovative projects designed to benefit Israeli society and humanity as a whole – from nanotechnology through novel medical devices to assistive technologies for people with disabilities, and much more.
Multidisciplinary approach
At HIT we believe that ‘mixing ingredients’ leads to novel results that cannot be attained by each component separately. Consequently, our researchers collaborate with their colleagues in other Faculties, as well as experts from leading institutions, both in Israel and worldwide – to enhance mutual enrichment, generate innovative ideas, and open new paths to greater achievements. At the same time, HIT students are exposed to multidisciplinary contents, practices, and principles through our School of Multidisciplinary Studies – where students from different Faculties take courses together, enrich one another, and create joint projects that express their different fields of knowledge.
Higher education for all
We place special emphasis on support for students from the country’s social and geographic peripheries.